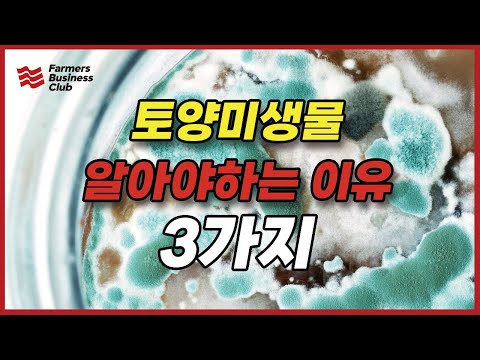
[🧑‍🌾농프로] 토양미생물을 알아야하는 이유 3가지

4. 토양관리, 인접산 부엽토처럼(초 다수확 핵심기술을 담은 최신 강좌가 대전 에서 진행) -JADAM Organic Farming

JADAM Organic Farm & Garden
View ChannelAbout
No channel description available.
Latest Posts
No results found. Try different keywords.
Video Description
JADAM Books(amazon) : https://amzn.to/3kZrw1L JADAM Brief Introduction: https://bit.ly/2UVU0yJ JADAM Amazon : https://amazon.com/jadam 유기재배 다수확 핵심기술을 담은 '2019' 최신 천연농약 전문강좌가 대전에서 열리고 있습니다. 강좌, 책, 원재료 문의 : 1899-5012, www.jadam.kr JADAM books are available for purchase from Amazon.com worldwide. It is currently translated into English, Italian, Chinese, Japanese and Korean and will be translated into various languages in the future. About Youngsang Cho Youngsang Cho is Organic Farmer. Cho learnt Natural Farming from his father Hankyu Cho(Korea Natural Farming, KNF) who advocated an environmentally agriculture since 1960s. Cho family have been organic farming for the third generation. Cho served in 706 special forces and graduated from Aju University (Bachelor, Chemistry) and Chungnam National Uni (Master, Horticulture). Cho has entered the Ph.D. course from the Department of Agricultural Biology at Chonbuk National University. Cho started organic agriculture in 1989. Through decades of practice and research, he created a new Ultra-Low-Cost organic agriculture system based on his father's farming and Asian traditional farming. He founded “JADAM” in 1991. In 2019, JADAM's membership exceeded 70,000. Youngsang Cho’s inventions (All inventions are contained in the JADAM Organic Farming book) : JADAM Wetting Agent (made without heating), JADAM Sulfur (made without heating), JADAM Microorganism Solution made with potatoes, JADAM Microorganism Solution made with mixed grains,Natural pesticide against rice bakanae disease, Natural germicide against anthracnose, & leaf spot, Natural fungicide against powdery mildew & downy mildew, Natural pesticide against aphids & mites, Natural pesticide against tobacco moth & beet armyworm, Natural pesticide against stinkbug & mealybug, Natural pesticide against slug & snail, Natural pesticide against citrus flatid planthopper, Natural pesticide against rice water weevil, Eliminating flies from livestock housings, Naphthalene pesticide, Natural pesticide against chicken lice, Natural pesticide against coffee berry borers ,Natural pesticide against papaya mealybugs. JADAM’s ultimate objective is to bring farming back to farmers. Through JADAM’s method, farming can become Ultra-Low-Cost, completely organic, and farmers can once again become the masters of farming. Farmers will possess the knowledge, method and technology of farming. When organic farming becomes easy, effective and inexpensive, it can finally become a practical alternative. Farmers, consumers and Mother Nature will all rejoice in this splendid new world we wish to open. Let's all move forward with Ultra Low-Cost agriculture. JADAM overcome completely the technical and practical challenges of organic agriculture. Make your own All Powerful Natural Pesticides, microbial inputs and fertilizers. JADAM aims to create Agricultural Revolution with Ultra-Low-Cost agriculture in the world. Our farming have to Independent from Commercial monopoly corporation. FARMERS must take the INITIATIVE in agricultural technology. Ingredients for JADAM : http://en.jadam.kr/com/ingredient.html Youtube : https://bit.ly/2lTXcsK Facebook : https://www.facebook.com/jadam.korea Instagram : https://www.instagram.com/jadamorganic_official JADAM Website: http://m.en.jadam.kr #총채벌레 #진딧물 #응애 #나방 #담배나방 #파밤나방 #배추흰나비 #노린재 #꽃매미 #갈색날개매미충 #선녀벌레 #탄저병 #흰가루병 #잎마름병 #노균병 #시듬병 #둥근무늬낙엽병 #병해충방제 #미생물배양 #무경운 #thrips #aphids #mite #moth #tobaccomoth #cabbagewhitebutterfly #stinkbug #flowercicada #anthracnose #powderyblight #leafblight #downymildew #wiltdisease #leafblight #blackspot #PestControl #diseasecontrol #microbial culture #no-till
Upgrade Your Everyday
AI-recommended products based on this video

Kasa Smart Outdoor Smart Plug by TP-Link (KP400) - Smart WiFi Outlet with 2 Sockets, IP64 Waterproof, Works with Alexa and Google Home, 2.4GHz WiFi Required, No Hub Required, Sunset & Sunrise Offset

Wireless Earbuds, Sports Bluetooth Headphones, 80Hrs Playtime Ear Buds with LED Power Display, Noise Canceling Headset, IPX7 Waterproof Earphones for Workout/Running(Black)

Wireless Earbuds, Bluetooth 5.4 Headphones HiFi Stereo with 4 HD Mic, 50H Playtime Bluetooth Earbuds with LED Display, IPX7 Waterproof Wireless Earphones, Touch Control Ear Buds,USB-C White

Wireless Earbuds, Bluetooth Ear Buds 5.4 Mini HiFi Stereo with 4 ENC Noise Cancelling Mics Wireless Headphones, in Ear Earphones 40H IP7 Waterproof, USB C, Bluetooth Earbuds for Sports, Gym, Rose

soundcore P31i by Anker, Real-Time Adaptive Noise Cancelling, Hi-Res Sound, Translation Earbuds, 50H Playtime, Wireless Earbuds, Bluetooth Earphones, Spatial Audio, Fast Charging, IP55 ClimatePartner certified

Brita Stainless Steel Premium Filtering Water Bottle, BPA-Free, Reusable, Insulated, Replaces 300 Plastic Water Bottles, Filter Lasts 2 Months or 40 Gallons, Includes 1 Filter, Carbon - 20 oz.

Simple Modern Filtered Water Bottle | Insulated Stainless-Steel Carbon Filter Travel Water Bottles | Reusable for Clean Drinking Water On The Go | 24oz, Sea Glass Sage

FITVII Health & Fitness Tracker (Answer/Make Calls), Smart Watch with 24/7 Heart Rate and Blood Pressure, Sleep Tracking Monitor, 120+ Sport Mode Activity Tracker

AYATAHA AYATAHA Smart Watch for Kids, Smartwatch Fitness Tracker for Boys Girls, Children's Activity Watch 37 Sports Modes SMS Notification, HD Full Touchscreen IP67 Waterproof, Blue

Iaret Iaret Smart Watch for Women, 1.83" HD Fitness Tracker with 4 Bands, Answer/Make Calls, Heart Rate/Sleep/SpO2/Step Tracking, 100+ Sport Modes, Android/iPhone Compatible Gift (Rose Gold)

Smart Watch for Men Women 1.8" Fitness Tracker, Bluetooth Call, DIY Dial, Heart Rate Sleep Blood Oxygen Monitor, 100+ Sports Modes, IP68 Waterproof Smartwatch for Android iPhone, Alexa Built-in

Hand Warmers 2 Pack, 14000mAh Rechargeable Hand Warmers, Electric Hand Warmer Reusable, Portable Power Bank USB Hand Warmers 4 Levels 8 Heating, Gifts for Raynauds Ski Golf Camping

Hand Warmers Rechargeable, 10000mAh Electric Heated Gloves Power Bank Portable Graphene Handwarmers Pouch with 3 Levels & Double-Sided Heating for Hunting Camping Golf Xmas Gifts for Women Men Kids

2Pack Rechargeable Hand Warmer, 8000mAh Electric Hand Warmer Power Bank, Portable USB-C Hand Warmer for Pocket, Reusable Hand Warmer Up to 8 hrs Each, Warm Gift for Men Women, for Hunting, Camping

GTOCE Portable Charger,40000mAh Power Bank with 22.5W Fast Charging LED Digital Display Battery Pack with 6 Outputs 2 Inputs, Type C Powerbank Portable Charger for iPhone 16 pro Samsung AirPods,Black

YMZ Smart Watch for Men Women, IP68 Waterproof, Bluetooth Calling, Fitness Tracker, Sleep Monitoring, 1.85'' DIY Dial, AI Built-in, 100+ Sports Modes, 7 Days Battery, Compatible with Android & iPhones

Smart Watch for Men Women 1.8" Fitness Tracker, Bluetooth Call, DIY Dial, Heart Rate Sleep Blood Oxygen Monitor, 100+ Sports Modes, IP68 Waterproof Smartwatch for Android iPhone, Alexa Built-in

Smart Watch for Men Women with Bluetooth Call, Alexa Built-in, Heart Rate & Sleep Monitor, 1.83" DIY Dial Fitness Watch with 100+ Sport Modes, IP68 Waterproof, Compatible with Android iOS

Smart Watch for Men Women with Bluetooth Call, Alexa Built-in, Heart Rate & Sleep Monitor, 1.83" DIY Dial Fitness Watch with 100+ Sport Modes, IP68 Waterproof, Compatible with Android iOS

Hydroponics Growing System Indoor Garden - Herb Garden with Grow Light, 15 Pods Stainless Steel Indoor Garden Kit, Auto Timer, Gardening Gift for All Ages

Umbra Triflora Hanging Planter for Window, Indoor Herb Garden, Set of 5, White/Black

Large Hydroponics Growing System 14 Pods, Indoor Herb Garden with LED Grow Light, 5L Water Tank, Hydroponic Grow Kit with 3 Auto-Timers, Rotatable Light Panel and Child Lock for Home School Gardening

Hanging Planter Hanging Plant Holder, 6 Inch 4 Indoor Plant Pots, Wall/Window Plant Hanger Indoor Herb Garden

Ninja Air Fryer Pro 5-in-1, 5 QT Capacity, Air Fry, Bake, Roast, Reheat, and Dehydrate, Air Crisp Technology, Nonstick Basket & Crisper Plate, Grey, AF142C

Glass Oil Sprayer for Cooking, 180ml Olive Oil Sprayer Bottle with Brush, Olive Oil Spray Mister, Kitchen Gadgets Accessories for Air Fryer, Canola Oil Spritzer (GREY)

Hi.FANCY Portable Laptop Stand with Dual Cooling Fans for 14-17inch Laptops, Grey, 23.5 x 25.9 x 0.95cm

Laptop Stand for Desk, Adjustable Laptop Riser ABS+Silicone Foldable Portable Laptop Holder, Ventilated Cooling Notebook Stand for 10-15.6” Laptops,Tablet-Black

JETech 5 in 1 Case for Samsung Galaxy S25 Ultra 5G with 2-Pack Each Tempered Glass Screen Protector and Camera Lens Protector, Non-Yellowing Shockproof Bumper Phone Cover (Clear)

TAURI for iPhone 17 Pro Max Case 6.9" with 1-Pack Screen Protector, Camera Lens Full Protection, Military-Grade Protection, Shockproof Transparent Back Bumper Phone Cover - Clear Global Recycled Standard

TAURI for iPhone 17 Pro Case 6.3" with 1-Pack Screen Protector, Camera Lens Full Protection, Military-Grade Protection, Shockproof Transparent Back Bumper Phone Cover - Clear Global Recycled Standard

JOINPAYA 1Set Rechargeable Hand Warmer Hand Heater for Winter Heating Levels Compact

Shakven Rechargeable Hand Warmer | Cute Comfortable Portable Hand Warmers,Ergonomic Adjustable Energy-Efficient Small Heater for Travel, Outdoor, Winter

OCOOPA IP45 Waterproof Hand Warmer Rechargeable, Up to 15hrs Heat,10000mAh Durable Quick Charge Electric Hand Heater, PD Compatible, 3 Levels for Outdoors, Heavy Duty, H01-PD PRO





![[🧑🌾농프로] 토양미생물을 알아야하는 이유 3가지](https://imgz.pc97.com/?width=500&fit=cover&image=https://i.ytimg.com/vi/UuWBKgBcnz0/hqdefault.jpg)

![웃음이 멈추질 않네! 부여에 이런 분이? [부여 만수리] 첫번째 이야기](https://imgz.pc97.com/?width=500&fit=cover&image=https://i.ytimg.com/vi/W6dhNjQ0VNQ/hqdefault.jpg)